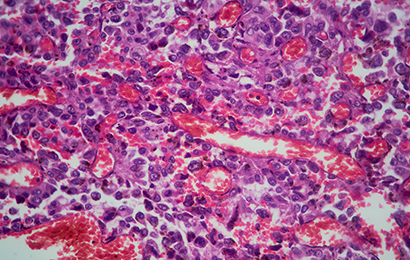
Nierenkrebs Kartenbild

Gemeinsam Krebs
den Schrecken nehmen
Pfizer setzt sich dafür ein, dass Menschen mit Krebs länger und besser leben. Deshalb arbeiten wir an der Entwicklung innovativer Medikamente und Lösungen, um Krebs früher erkennen und erfolgreich behandeln zu können.
Unsere Expertise bei den häufigsten Krebsarten

Brustkrebs
Wir verfolgen verschiedene Therapieansätze, um möglichst vielen Brustkrebspatient:innen zu helfen.

Lungenkrebs
Wir fokussieren uns auf zielgerichtete Medikamente, um Lungenkrebs effektiv zu behandeln.

Blutkrebs
Wir konzentrieren uns auf neue Behandlungsansätze, die direkt bei den Krebszellen ansetzen.

Prostatakrebs
Wir setzen uns dafür ein, die Versorgung mit innovativen Therapien zu verbessern.
Nierenkrebs
Wir bieten moderne Therapiekombinationen, die auch im fortgeschrittenen Stadium eingesetzt werden können.
Eine Geschichte der medizinischen Durchbrüche
Seit Jahrzehnten entwickelt Pfizer lebensverändernde Therapien. Auch unseren Kampf gegen Krebs setzen wir konsequent fort: Weltweit investieren wir 40 % unserer Ausgaben für Forschung- und Entwicklung (F&E) in den Bereich Onkologie.
Erfahren Sie mehr über unsere Meilensteine.

2024
Start von Phase-III-Studien zur Untersuchung potenzieller neuer Medikamente in den Bereichen Lungenkrebs, Brustkrebs und Prostatakrebs.

2024
Die Ergebnisse klinischer Studien zu ALK-positivem (ALK = Anaplastische Lymphomkinase), nicht-kleinzelligem Lungenkrebs (NSCLC) deuten auf vielversprechende Fortschritte in der Therapie von Lungenkrebs hin.

2024
Ein Medikament, das das sogenannte Poly (ADP-Ribose) Polymerase (PARP)-Protein auf Krebszellen hemmt, wird in Kombination mit einem etablierten Arzneimittel zur Behandlung einer fortgeschrittenen Form von Prostatakrebs zugelassen.

2023
Durch die Übernahme von Seagen erweitern wir unser Angebot mit führenden Technologien im Bereich der Antikörper-Wirkstoff-Konjugate und verdoppeln die Anzahl unserer klinischen Studien in der Onkologie.

2023
Ein sogenannter bispezifischer Antikörper, der das körpereigene Immunsystem nutzt, um das rezidivierte und refraktäre Multiple Myelom zu behandeln, wird zugelassen.

2023
Bahnbrechende Ergebnisse einer klinischen Studie zur Kombination eines Antikörper-Wirkstoff-Konjugats und einer Immuntherapie zeigen das Potenzial, die Behandlung von fortgeschrittenem Blasenkrebs grundlegend zu verändern.

2020
Das erste Medikament, das gezielt Darmkrebszellen mit einer bestimmten Genmutation angreift, die eine entscheidende Rolle bei Darmkrebs spielen, wird in den USA zugelassen.

2019
Ein Medikament gegen ALK-positiven (ALK = Anaplastische Lymphomkinase) Lungenkrebs wird zugelassen. Es kann häufig auftretende Resistenz-mutationen, die die Wirkung anderer Medikamente beeinträchtigen, überwinden.

2016
Ein innovatives Medikament für Menschen mit metastasiertem Brustkrebs (mBC) wird zugelassen – der erste Fortschritt bei mBC seit mehr als 10 Jahren.

2012
Das erste Medikament zur Hemmung abnormer ALK-Proteine (ALK = Anaplastische Lymphomkinase) bei Lungenkrebs wird zugelassen.
Fortschritt beschleunigen
Jede Minute zählt: Pfizer unterhält derzeit weltweit mehr als 55 Programme für neuartige Krebstherapien, die sich in der Entwicklung befinden. Im Rahmen dessen werden weltweit 25 Zulassungen in den kommenden fünf Jahren erwartet. Bis Ende 2028 sind allein in Deutschland acht Zulassungen geplant. Durch präzise Forschung entwickeln wir dabei immer zielgerichtetere Medikamente, die Krebszellen erkennen und zerstören, ohne den ganzen Körper zu belasten.
Antikörper-Wirkstoff-Konjugate, auch „ADCs“ (antibody-drug conjugates) gehören zu den zielgerichteten Therapien. Sie bringen zelltötende Wirkstoffe direkt in die Krebszelle ein.
Immuntherapien unterstützen die körpereigene Abwehr, Krebszellen besser zu erkennen und zu bekämpfen. Eine spezielle Form der Immuntherapie sind die bispezifischen Antikörper.
Als Bestandteil der personalisierten Medizin richten sich zielgerichtete Therapien gegen bestimmte molekulare Besonderheiten von Tumorzellen, die relevant für deren Wachstum sind.

Innovative Krebsmedikamente – Made in Germany
In Deutschland stellt Pfizer mehr als 20 Medikamente zur Behandlung von Krebs zur Verfügung, beispielsweise gegen bestimmte Formen von Brust-, Lungen-, Blut- und Nierenkrebs. Dazu zählen mehr als zehn zielgerichtete Therapien und das breiteste Portfolio an onkologischen Biosimilars – das sind Medikamente, die sehr ähnlich zu bereits zugelassenen biologischen Arzneimitteln („Originalpräparaten“) sind. Sie werden hergestellt, wenn das Patent des Originalpräparats abgelaufen ist, und haben die gleiche therapeutische Wirkung wie das Originalpräparat, sind aber oft günstiger.
Die Mehrzahl der Krebsmedikamente, die Pfizer in Deutschland und mehr als 180 Ländern weltweit anbietet, wird in Freiburg im Breisgau produziert. Das sogenannte Pfizer Zukunftswerk ist eine der größten und modernsten Produktionsstätten der pharmazeutischen Industrie. Hier werden automatisierte Verfahren entwickelt, um innovative Medikamente flexibel und schnell in sehr großen oder kleinen Mengen herzustellen.
„Grüne“ Medikamentenherstellung
Die Freiburger Produktionsstätte ist auch als „die grüne Fabrik“ bekannt. Dank über 200 Maßnahmen, die dazu dienen, Ressourcen und Energie zu sparen, ist das Werk führend in umweltfreundlicher und nachhaltiger Medikamentenproduktion. Laut Umweltbundesamt ist es damit ein Vorbild für nachhaltige Arzneimittelherstellung. Auch bei den Energiequellen wird auf Nachhaltigkeit gesetzt mit Holz-Pellets, Geothermie und Solarenergie.

Krebsprävention und
-früherkennung
In Deutschland erkrankt jede:r Zweite im Laufe des Lebens an Krebs.1 Dabei geht die WHO davon aus, dass sich 30 bis 50 % aller Krebsneuerkrankungen durch einen gesünderen Lebensstil und Vorsorge verhindern ließen. Gesunde Ernährung, Bewegung, wenig Alkohol und Nichtrauchen spielen dabei eine wichtige Rolle.2
Auch die Früherkennung von Krebs kann Leben retten,2 sie wird aber noch in vielen Bereichen zu wenig in Anspruch genommen. Zusammen mit einem interdisziplinären Fachgremium hat Pfizer deshalb den Präventionsindex ins Leben gerufen, der dazu beitragen soll, die Präventionsarbeit in Deutschland messbar und transparenter zu machen.
Ein besonderer Fokus liegt dabei auf der Onkologie, da hier der Bedarf an konkreten Plänen zur langfristigen Verbesserung besonders hoch ist. Eine erste Auswertung im Bereich Onkologie zeigte bereits: Nur ein knappes Drittel der diagnostizierten Brustkrebsfälle in Deutschland geht auf ein Brustkrebsscreening zurück, der Rest sind Zufallsbefunde.3 Das Ergebnis unterstreicht das enorme Verbesserungspotenzial im Bereich Prävention.
Unsere Mission: Krebs den Schrecken nehmen

Referenzen:
- Robert Koch-Institut (Hrsg.). Zentrum für Krebsregisterdaten. Krebs in Deutschland für 2019/2020. Online verfügbar unter: https://www.krebsdaten.de/Krebs/DE/Content/Publikationen/Krebs_in_Deutschland/krebs_in_deutschland_2023.pdf. Letzter Zugriff am 17.04.2025.
- World Health Organization (WHO). Online verfügbar unter: https://www.who.int/news-room/fact-sheets/detail/cancer. Letzter Zugriff am 17.04.2025.
- Prävention in der Onkologie. Contract Research Report. November 2024.


